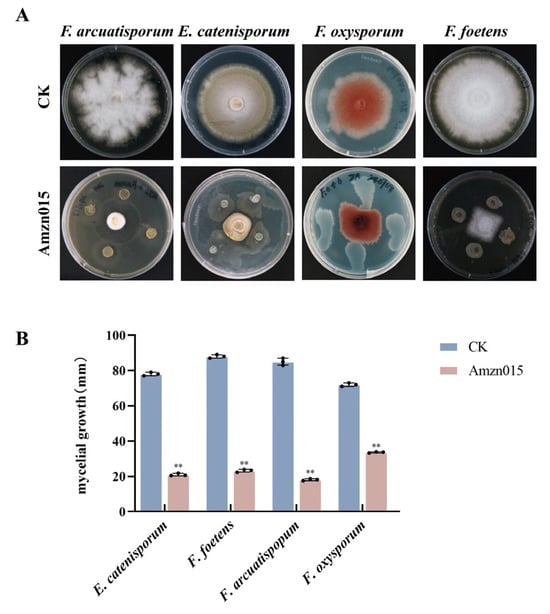

Abstract
Atractylodes macrocephala Koidz. (A. macrocephala), a medicinal plant extensively used in traditional Chinese medicine, is greatly susceptible to root rot under continuous monoculture, leading to serious yield and quality losses. To develop a sustainable control strategy, we isolated the endophytic bacterium Bacillus velezensis (B. velezensis) Amzn015 from healthy A. macrocephala plants and assessed its biocontrol efficacy and underlying mechanisms. In vitro assays showed that Amzn015 significantly inhibited Fusarium oxysporum and other phytopathogenic fungi by disrupting hyphal morphology and reducing spore viability. Pot experiments confirmed its effectiveness in reducing disease incidence and promoting plant growth. Mechanistically, Amzn015 induced reactive oxygen species accumulation and upregulated key defense responsive genes involved in salicylic acid, jasmonic acid/ethylene, and phenylpropanoid signaling pathways. The findings imply that Amzn015 synchronously activates systemic acquired resistance and induced systemic resistance in A. macrocephala. This dual activation contributes to enhanced immunity and plant vigor under pathogen challenge. Our findings offer fresh perspectives on the biocontrol potential of endophytic B. velezensis Amzn015 and support its application as an eco-friendly agent for managing root rot in medicinal crops.
1. Introduction
Atractylodes macrocephala Koidz. (A. macrocephala) is a perennial herb of the genus Atractylodes in the family Asteraceae, and its dried rhizome serves as a fundamental medicinal ingredient in traditional Chinese medicine. It is widely used for its core therapeutic functions, including tonifying the spleen, replenishing qi, dispelling dampness, and promoting diuresis [1]. The total cultivation area of A. macrocephala in China exceeds 200,000 mu (one mu is approximately equal to 666.67 square meters), with major production regions including Anhui, Jiangxi, Henan, Hebei, Hubei, and Zhejiang. Among these, A. macrocephala from Zhejiang is especially renowned for its geo-authenticity and superior quality [2]. However, long-term continuous cropping has led to severe growth disorders in A. macrocephala, such as plant dwarfism, leaf chlorosis, and fibrous root degradation. These issues have significantly limited its yield and quality, posing a major bottleneck to the sustainable utilization of this valuable medicinal resource and hindering the development of its cultivation industry.
One of the most critical challenges associated with continuous cropping of A. macrocephala is root rot, which has become the primary disease restricting its sustainable cultivation. Typical symptoms include longitudinal cracks, damage to the root epidermis with cambial tissue necrosis, light-brown lesions and black spots, and the emergence of white, flocculent mycelia on the root surface [3]. In severely affected regions, root rot can cause production losses of up to 60%. Studies have shown that Fusarium spp. dominate the rhizosphere and endophytic fungal communities of diseased plants, posing a serious threat to A. macrocephala health [4]. Current disease management strategies primarily rely on chemical pesticides, which carry the risks of environmental residues and the development of pathogen resistance [5]. Al Raish et al. pointed out that the practical application of plant-growth-promoting microorganisms (PGPMs) in agriculture is constrained by multiple factors, including the instability of field performance, limited survival and colonization under natural environmental conditions, and obstacles related to regulatory approval and application methods [6]. In contrast, green and efficient biological control approaches remain underdeveloped and are urgently needed.
In this context, endophytes—symbiotic microorganisms residing within plant tissues—have attracted increasing attention for their ability to promote host health through diverse mechanisms. These include direct antagonism against phytopathogens [7], stimulation of plant growth [8], and increase in stress tolerance [9]. Among them, Bacillus velezensis (B. velezensis) has emerged as a particularly promising biocontrol agent due to its capacity to produce a wide array of antimicrobial compounds, such as lipopeptide antibiotics and cell wall-degrading enzymes [10], Several strains have demonstrated notable efficacy in agricultural applications: B. velezensis 8-2 effectively reduces the disease index of cherry leaf curl [11], B. velezensis SX13 promotes cucumber growth [12], and B. velezensis F9 enhances cucumber seedling vigor via indole-3-acetic acid (IAA) secretion and nitrogen fixation [13]. These findings suggest that B. velezensis strains possess diverse functional traits conducive to sustainable crop protection and productivity.
Despite these advancements, the application of B. velezensis in the biological control of A. macrocephala root rot remains insufficiently explored, particularly in the context of alleviating continuous cropping-related obstacles. It remains unclear whether specific strains such as Amzn015 can effectively mitigate Fusarium infection by synergistically activating induced systemic resistance (ISR). Addressing this knowledge gap is critical for developing green disease management strategies and ensuring the safety and quality of medicinal plant resources.
In this study, the endophytic strain B. velezensis Amzn015 was isolated from healthy A. macrocephala plants in Zhejiang Province. Its antagonistic activity against Fusarium oxysporum (F. oxysporum), along with its growth-promoting and resistance-inducing capabilities, was systematically investigated. We further explored the underlying mechanisms by which Amzn015 enhances host defense, focusing on its ability to regulate reactive oxygen species (ROS) metabolism and activate systemic resistance pathways. This work aims to provide both theoretical insights and practical strategies for the eco-friendly control of A. macrocephala root rot and to support the sustainable cultivation of this important medicinal crop under continuous cropping conditions.
2. Materials and Methods
2.1. Sample Preparation and Microbial Isolation
Rhizome samples of A. macrocephala were collected from a cultivation base in Panan, Zhejiang Province. After washing with tap water and sterile distilled water, the samples were surface-sterilized by sequential immersion in 3% NaClO for 1 min and 75% ethanol for 3 min, followed by three thorough rinses with sterile water. To assess the effectiveness of surface sterilization, 100 μL of the final rinse water was collected, spread onto lysogeny broth (LB) agar plates (Hangzhou Microbial Reagent, Hangzhou, China), and incubated to detect microbial growth. The sterilized rhizomes were then homogenized using an automatic rapid sample grinder (Shanghai Jingxin, Shanghai, China), and the resulting homogenate was subjected to a 10-fold serial dilution (10−1 to 10−5). Aliquots (100 μL) of each dilution were spread onto LB agar plates and incubated at 37 °C for 24 h to isolate rhizosphere-associated microorganisms. Individual colonies were purified, assigned serial numbers beginning with Amzn001, and stored in 80% (v/v) glycerol at −80 °C for future use.
2.2. Preliminary Screening of Antagonistic Bacteria Against F. oxysporum
A strain of F. oxysporum was obtained from Chuanglian Biotechnology Institute (Chaoyang District, Beijing, China). The optimal antagonistic bacterial strains were screened using a dual-culture plate assay [14]. F. oxysporum was cultured on potato dextrose agar (PDA) at 28 °C. An 8 mm diameter mycelial plug was taken from the edge of an actively growing colony using a sterile cork borer and placed at the center of a fresh PDA plate. Ten microliters of fermentation broth from each bacterial isolate was then spotted in a cross (“+”) pattern 2 cm away from the fungal plug, while an equivalent volume of LB medium served as the negative control. Plates were incubated at 28 °C for up to 9 days, or until the control fungus had fully overgrown the plate. After incubation, the colony radius of F. oxysporum was measured on both the control plate (Rck) and the treatment plate (Rd). We calculated the inhibition rate (V) with the following expression: V = [(Rck−Rd)/(Rck−Rm)] × 100 [15], where Rck is the colony radius on the control plate, Rd is the colony radius on the treatment plate, and Rm is the radius of the initial fungal disc (Rm = 4 mm), all measured in millimeters.
2.3. Verification of Broad-Apectrum Antagonistic Activity
To verify the inhibitory spectrum of the optimal antagonistic endophytic bacterium against other pathogenic fungi associated with continuous cropping obstacles in A. macrocephala, a dual-culture plate assay was conducted as described above. The antagonistic activity was tested against three fungal pathogens previously isolated from diseased A. macrocephala plants in our laboratory: Fusarium foetens, Epicoccum catenisporum, and Fusarium arcuatisporum. The molecular identification of these pathogens is shown in Supplementary Figure S1. All fungal strains used in this assay were preserved in our laboratory culture collection.
2.4. Morphological and Molecular Identification of Amzn015
Gram staining was conducted as described [16]. The strain was incubated on LB agar at 37 °C for 18–24 h, and its cell morphology was then examined with a light microscope (CX40, Sunny Group, Zhejiang Province, China). Genomic DNA was extracted using a commercial kit (Tiangen, Beijing, China), and the 16S rRNA gene was amplified using primers reported previously [17]. The amplified products were sequenced on an Illumina HiSeq 2500 platform (Illumina, San Diego, CA, USA) at Zhejiang Easy-Decode Biotechnology Co., Ltd. The resulting sequences were analyzed using BLAST (National Center for Biotechnology Information) and GraphPad Prism software (version 9.5.0; GraphPad Software, San Diego, CA, USA) for homology comparison. Subsequently, a phylogenetic tree was constructed with the neighbor-joining algorithm in MEGA version 11 (www.megasoftware.net; accessed on 17 December 2024). Whole-genome sequencing of Amzn015 was conducted on the PacBio platform (BGI, Wuhan, China). High-quality DNA was extracted from three independent bacterial samples (DNA integrity number ≥7.0; concentration ≥20 ng/μL), followed by library preparation and sequencing. Reads were aligned to a reference genome using BWA (Burrows-Wheeler Aligner, version v0.7.17), and variant calling was performed with GATK (Genome Analysis Toolkit, version v4.4.0.0). The raw sequencing data have been deposited in the NCBI database under accession number PRJNA1294532.
2.5. Assessment of Amzn015’s Plant Growth Capabilities
To investigate the plant-growth-promoting mechanisms of strain Amzn015, its nitrogen fixation ability, siderophore production, and phosphate solubilization capacity were assessed following the established methods [18]. IAA production was quantified using the Salkowski colorimetric assay as described in the cited protocol [19].
2.6. Effects of Amzn015 on Spore Germination, Viability, and Hyphal Morphology of F. oxysporum
2.6.1. Effect on Spore Germination
An equal volume of Amzn015 bacterial suspension (in logarithmic phase) and F. oxysporum spore suspension (107 CFU/mL) was mixed at a 1:1 ratio and co-incubated in a 96-well plate for 12 h. The control group received an equal volume of LB medium instead of bacterial suspension. Spore germination was monitored by light microscopy, and both total and germinated spores were quantified using a hemocytometer (Biosharp, Anhui, China). Germination rate was calculated accordingly, and each treatment was conducted in triplicate.
2.6.2. Assessment of Spore Viability by Evans Blue Staining
Amzn015 and F. oxysporum suspensions (both at 108 CFU/mL) were added to potato dextrose broth (PDB; Hangzhou Microbial Reagent, Hangzhou, China) to a final concentration of 3% (v/v) and co-cultured for 3 days. Mycelia were removed using sterile gauze (Solarbio, Beijing, China), and the resulting spore suspension was stained with 0.05% Evans Blue and incubated at ambient temperature for 10 min [20]. Spores were then observed under a light microscope, and Viable spores were quantified using a hemocytometer, and these counts were used to calculate the survival rate. The control group received an equal volume of sterile PDB.
2.6.3. Scanning Electron Microscopy (SEM) Observation of Hyphae
To observe hyphal morphology, Amzn015 and F. oxysporum were co-cultured using the dual-culture plate assay described above. Hyphae from the interaction zone were collected and fixed in 1.5% glutaraldehyde at room temperature (approximately 20–25 °C) for 1–2 h. The samples were washed three times with distilled water and then dehydrated using 90% tert-butanol. After dehydration, samples were placed in a vacuum freeze dryer (VFD-21S, SHINKKU VD, Fujisawa, Japan) for 2 h and observed under a scanning electron microscope (SU8010, Hitachi, Japan). Micrographs were recorded as described [21].
2.7. Assessment of the Effects of Amzn015 on the Germination and Seedling Performance of A. macrocephala
Healthy seeds of A. macrocephala were selected and surface-sterilized by immersion in 3% NaClO for 1 min and 75% ethanol for 3 min, followed by five rinses with sterile water. Seeds were blotted dry on sterile filter paper. Strain Amzn015 was cultured in LB broth at 37 °C with shaking until the logarithmic phase, after which bacterial cells were harvested by centrifugation and resuspended in sterile PBS to a final concentration of 108 CFU/mL. Sterile filter paper was placed in Petri dishes, and 5 mL of bacterial suspension was added; the control group received 5 mL of PBS. Fifteen sterilized seeds were evenly placed in each dish. Plates were incubated in a growth chamber (Boxun, Shanghai, China) at 25 ± 1 °C with a 16 h light/8 h dark photoperiod and maintained at 70% relative humidity. Water lost to evaporation was replenished daily. On day 12, we determined germination percentage (GP%) using the equation: GP (%) = (number of germinated seeds/total seeds) × 100 [22]. Germinated seeds were transplanted into a sterilized soil mix consisting of vermiculite, perlite, and sterile soil in a 1:1:3 ratio. At the two-leaf stage, entire seedlings were carefully removed. Roots were rinsed to remove attached soil and submerged in water to fully straighten. Root length and shoot height were measured using a ruler. Shoot height was defined as the distance from the soil surface to the tip of the tallest leaf. Whole seedlings were submerged in distilled water within sealed bags for 24 h to attain full turgor. After removing excess moisture with filter paper, fresh weight was measured. The seedlings were then cut into small pieces, placed in glass Petri dishes, and dried in a forced-air oven at 115 ± 10 °C for 30 min, followed by further drying at 65 °C for 6 h until a constant weight was reached. Dry weight was recorded using an electronic balance (Shimadzu ATX224R, Kyoto, Japan).
2.8. Assessment of Disease Index in A. macrocephala Following F. oxysporum Infection with or Without Amzn015 Induction
Healthy six-week-old A. macrocephala seedlings at the two-leaf stage were selected for pot experiments. F. oxysporum was cultured on PDA plates at 28 °C for 7 days. Mycelia from the colony edge were transferred to PDB and incubated at 28 °C with shaking at 180 rpm (THZ-98A, Shanghai, China) for 5 days. The culture was filtered through 12 layers of sterile gauze to remove mycelia, and the resulting spore suspension was adjusted to 108 CFU/mL in sterile PBS using a hemocytometer. Strain Amzn015 was initially cultured on LB agar plates at 37 °C for 12 h and a single colony was inoculated into LB broth and incubated at 37 °C with shaking at 180 rpm for 48 h. The bacterial suspension was then adjusted to 108 CFU/mL with sterile PBS. Two-leaf-stage seedlings were transplanted into sterile plastic pots containing a soil mix of vermiculite: perlite: sterile soil (1:1:3). Roots were rinsed with sterile water and plants were divided into four groups, each transplanted into individual pots. Seven days before fungal inoculation, the Amzn015 treatment group was root-drenched with 10 mL of Amzn015 suspension (108 CFU/mL). The co-treatment group (Amzn015 + F. oxysporum) and the infection control group (F. oxysporum) were inoculated by root-drenching with 10 mL of F. oxysporum spore suspension (108 CFU/mL). Once obvious disease symptoms appeared on the leaves, Amzn015 suspension (10 mL) was applied to the co-treatment group by root drenching. The PBS control group (CK) received an equal volume of sterile PBS. Whole seedlings from all treatments were harvested at 0, 6, 12, 24, and 48 h post-inoculation, wrapped in aluminum foil, snap-frozen in liquid nitrogen, and stored at −80 °C for further analysis. Leaf disease severity was evaluated on day 65 using a 0–4 scale based on the proportion of symptomatic (yellowing or wilting) leaves as follows: 0 = no symptoms; 1 = 1–33% of leaves affected; 2 = 34–66% of leaves affected; 3 = 67–100% of leaves affected; 4 = whole plant dead. This scoring system followed the method described by Tang et al. [23]. The disease index and relative control efficacy were calculated using the following formulas: Disease index (DI, %) = [∑ (number of plants in each category × corresponding score)/(total number of plants × highest score)] × 100. Control efficacy (%) = [(disease index in control−disease index in treatment)/disease index in control] × 100 [24].
2.9. Determination of Defense Enzyme Activities in A. macrocephala Induced by Amzn015
To verify the resistance induced by Amzn015 in A. macrocephala, defense enzyme activities were measured in infected seedlings [23]. Seedlings from both control and treatment groups were collected at 0, 6, 12, 24, and 48 h post-inoculation. Roots, stems, and leaves were harvested and homogenized on ice using a tissue grinder, with a tissue mass (g) to extraction buffer volume (mL) ratio of 1: 10. The homogenates were centrifuged at 8000 rpm for 10 min at 4 °C, and the supernatants were transferred to 1.5 mL centrifuge tubes for enzyme assays. Peroxidase (POD), superoxide dismutase (SOD), catalase (CAT), superoxide anion radical (O2−), and malondialdehyde (MDA) levels were determined using commercial assay kits (Solarbio, Beijing, China) in accordance with the manufacturer’s instructions. Reaction reagents were added to both control and measurement tubes, mixed thoroughly, and absorbance (OD) values were measured using a microplate reader (Eppendorf D30, Berlin, Germany). Enzyme activities were calculated based on the respective formulas provided in the assay protocols.
2.10. RNA Extraction, cDNA Synthesis, and qPCR Analysis
Total RNA was isolated from plant material flash-frozen in liquid nitrogen using the FastPure Plant Total RNA Isolation Kit (Vazyme, Nanjing, China). RNA concentration and purity were measured with a NanoDrop One™ spectrophotometer (Thermo Fisher Scientific, MA, USA). One microgram of RNA was then reverse-transcribed into cDNA using the HiScript IV All—in—One Ultra RT SuperMix for qPCR (Vazyme). Quantitative real-time PCR (qRT–PCR) was carried out on a QuantStudio™ 3 system (Thermo Fisher Scientific, MA, USA) with SYBR Green I dye (Thermo Fisher) to quantify gene expression levels. The reaction system was set up based on established protocols described in previous studies [25]. The Amactin gene (actin) was used as the internal reference. Target genes analyzed included AmPR1 (pathogenesis-related protein 1), AmPAL (phenylalanine ammonia-lyase), AmERF1 (ethylene response factor 1), AmICS (isochorismate synthase), AmPR4 (pathogenesis-related protein 4), AmETR2 (ethylene receptor 2), AmPR2 (pathogenesis-related protein 2), AmNPR1 (nonexpressor of pathogenesis-related genes 1), AmJAR1 (jasmonate-resistant 1), AmC4H (cinnamate-4-hydroxylase), AmCAD (cinnamyl alcohol dehydrogenase), Am4CL (4-coumarate:CoA ligase), AmWRKY26, and AmWRKY22 (WRKY transcription factors). Primer sequences are listed in Supplementary Table S1. Amplification specificity was confirmed via melt-curve analysis and verified by agarose gel electrophoresis. Relative expression levels were calculated using the 2−ΔΔCT method [26] based on three biological replicates.
2.11. Statistical Analysis
One-way analysis of variance (ANOVA) was used to compare differences among groups. Graphs were generated using GraphPad Prism version 9.5.0 (GraphPad Software, San Diego, CA, USA). The results are presented as mean ± standard deviation (SD).
3. Results
3.1. Isolation of Endophytic Bacteria from A. macrocephala and Screening for Antagonistic Activity
A total of 46 endophytic bacterial strains (designated Amzn001–Amzn046) were isolated from the rhizomes of healthy A. macrocephala plants collected in Pan’an, Zhejiang Province. In vitro antagonism assays revealed that 10 of these isolates exhibited inhibitory activity against the root rot pathogen F. oxysporum (Figure 1). Among them, strain Amzn015 demonstrated the most pronounced antagonistic effect, with an average inhibition zone of 2.33 ± 0.08 cm (Supplementary Table S2).

Figure 1.
Dual culture assays of ten endophytic bacterial strains against F. oxysporum on PDA plates. (A) Schematic representation of the dual culture setup; (B–K) inhibition of F. oxysporum by strains Amzn001, Amzn007, Amzn011, Amzn012, Amzn014, Amzn015, Amzn041, Amzn044, Amzn045, and Amzn046, respectively; (L) F. oxysporum grown alone as a control. (n = 3).
In addition, Amzn015 exhibited strong antifungal activity against other common pathogens associated with A. macrocephala, including E. catenisporum, F. arcuatisporum, and F. foetens (Figure 2). Based on these results, Amzn015 was selected for further characterization in this study.
Figure 2.
Antagonistic activity of the biocontrol strain Amzn015 against four pathogenic fungi isolated from diseased A. macrocephala. (A) Dual-culture confrontation assays were performed on PDA plates. CK represents the control group, in which the pathogen was inoculated alone without any treatment. The four tested pathogens include F. oxysporum, F. foetens, E. catenisporum, and F. arcuatisporum. Clear inhibition zones indicate that Amzn015 exhibits strong antagonistic activity against all four pathogens. (B) Quantitative analysis of fungal diameter. (n = 3). ** p < 0.01.
3.2. Amzn015 was Identified as Bacillus velezensis
Strain Amzn015 formed milky white, circular colonies with diameters of 5–8 mm, irregular edges, and a dry, wrinkled surface (Figure 3A). Gram staining revealed that the cells were Gram-positive and rod-shaped (Figure 3B). The 16s rRNA gene sequence (PV972215) and whole-genome data (PRJNA1294532) for Amzn015 were obtained and deposited in the NCBI database (https://www.ncbi.nlm.nih.gov/genbank/, accessed on 17 July 2025). The circular genome map of Amzn015 is shown in Figure 3C. Phylogenetic analysis based on the 16s rRNA gene indicated that Amzn015 clustered within the Bacillus velezensis clade (Figure 3E). In addition, average nucleotide identity (ANI) analysis confirmed a high degree of genomic similarity (98–99%) between Amzn015 and reference strains of B. velezensis deposited in the NCBI database (Figure 3D). Taken together, the morphological characteristics and molecular evidence supported the identification of Amzn015 as Bacillus velezensis.

Figure 3.
Phenotypic, genomic, and phylogenetic characterization of strain Amzn015. (A) Colony morphology of Amzn015 on LB agar plates. (B) Gram staining observed under oil immersion microscopy; black arrows indicate Gram-positive bacteria. (C) Circular chromosome map of Amzn015 generated via the CGView server. (D) Average nucleotide identity (ANI) heatmap comparing Amzn015 with related bacterial genomes; both axes represent genome names, and values indicate ANI percentages. (E) Neighbor-joining phylogenetic tree based on 16s rRNA gene sequences, showing the evolutionary relationship between Amzn015 and closely related Bacillus strains. (n = 3).
3.3. Microscopic Evidence Reveals the Multitarget Antagonistic Mechanism of Amzn015
Evans Blue staining indicated that spores in the F. o group remained viable, showing minimal staining (Figure 4A), whereas spores treated with Amzn015 exhibited a markedly increased proportion of blue-stained cells (Figure 4B), suggesting a loss of membrane integrity and cell viability. Quantitative analysis showed that the spore survival rate in the F. o + Amzn015 group decreased by 70.8% compared to the control (Figure 4C). In addition, light microscopy revealed that Amzn015 significantly inhibited spore germination, compared with the F. o group, the germination rate of the F. o + Amzn015 group decreased by 35.8% (Figure 4D–F). Scanning electron microscopy (SEM) further confirmed the direct damaging effects of Amzn015 on F. oxysporum hyphae. Hyphae in the treated group exhibited severe shrinkage and deformation (Figure 4H), while those in the F. o group retained a smooth and turgid morphology (Figure 4G). These results collectively demonstrate that Amzn015 exerts a multitarget antagonistic effect on the pathogen by disrupting spore viability, inhibiting germination, and damaging hyphal structures.

Figure 4.
Microscopic observation of spore viability and hyphal morphology of F. oxysporum after treatment with Amzn015. (A,B) Evans blue staining of F. oxysporum spores under different treatments. The black arrow indicates viable spores, and the red arrow indicates non-viable spores. (F. o: F. oxysporum inoculation alone; F. o + Amzn015: combined treatment with Amzn015 and F. oxysporum.) (C) Quantitative analysis of F. oxysporum spore density. (D) Germination morphology of F. oxysporum spores. (E) Impaired germination morphology of F. oxysporum spores after Amzn015 treatment. (F) Statistical analysis of spore germination rates under different treatments. (G,H) SEM image of F. oxysporum hyphae under different treatment. (n = 3). ** p < 0.01.
3.4. Amzn015 Enhances Growth and Disease Resistance in A. macrocephala
Compared to the CK group, treatment with Amzn015 increased the seed germination rate of A. macrocephala by 22.2% (Figure 5C). Significant improvements were also observed in seedling growth parameters: shoot height increased by 16.6% (Figure 5E), root length by 63.5% (Figure 5F), dry weight by 72.0% (Figure 5G), and fresh weight by 40.9% (Figure 5H), indicating a robust plant-growth-promoting effect.

Figure 5.
Effects of strain Amzn015 on seed germination and seedling growth of A. macrocephala. (A) Representative image of seed germination under different treatments. The red box highlights the differences in root length among A. macrocephala seeds. (CK: distilled water control group; Amzn015: Amzn015 inoculation alone.) (B,C) Root length and germination rate of seeds. (D) Representative images of A. macrocephala seedling height under different treatments. The red box highlights the differences in shoot height among A. macrocephala seedlings. Quantitative analysis of root length (E), dry weight (F), fresh weight (G), and plant height (H) of seedlings after 20 days of growth. (n = 6). * p < 0.05, ** p < 0.01.
There was no significant difference in disease symptoms between the CK and the Amzn015 group (Figure 6A), indicating that Amzn015 itself was non-pathogenic to the host. The disease incidence of the F. o group reached 58.7%, while F. o + Amzn015 reduced the index to 19.9% (Figure 6D), resulting in a relative control efficacy of 66.2% (Figure 6C). In addition, the biomass of F. oxysporum in the F. o + Amzn015 group decreased by 33.0% (Figure 6E). Under pathogen stress, the F. o + Amzn015 group significantly mitigated growth suppression compared to the F. o group, with fresh weight increasing by 34.9% (Figure 6F), shoot height by 11.8% (Figure 6G), and root length by 14.1% (Figure 6H). These results suggest that Amzn015 not only suppresses root rot but also promotes plant recovery and growth under biotic stress.

Figure 6.
Pot experiment evaluating the biocontrol efficacy of strain Amzn015 against root rot of A. macrocephala. (A) Representative images of seedling phenotypes under different treatments. (CK: PBS control; F. o: F. oxysporum inoculation alone; Amzn015: Amzn015 treatment alone; F. o + Amzn015: combined treatment with Amzn015 and F. oxysporum.) (B–H) Disease progression and plant growth parameters were assessed 65 days post-inoculation, including: (B) disease index, (C) relative control efficacy, (D) disease incidence, (E) F. oxysporum biomass, (F) seedling fresh weight, (G) shoot height, and (H) root length. (n = 6). ** p < 0.01. ## p < 0.01.
3.5. Amzn015 Enhances Disease Resistance in A. macrocephala by Dynamically Regulating ROS Metabolism
A dynamic interplay exists in plants between ROS and the antioxidant defense system. In Figure 7A, seedlings of A. macrocephala in the F. o + Amzn015 group displayed a short-lived increase in O2− levels, along with progressive rises in SOD (Figure 7B) and POD activities (Figure 7C), while CAT activity gradually decreased (Figure 7D). This suggests that Amzn015 rebalances cellular oxidation, bolstering ROS-mediated defense during F. oxysporum infection. Meanwhile, lowered MDA levels point to reduced lipid peroxidation (Figure 7E), indicating mitigation of oxidative damage despite elevated ROS production. Overall, Amzn015 appears to modulate host oxidative stress by amplifying ROS generation and specific antioxidant enzyme activities, strengthening the plant’s defense while limiting cellular damage.

Figure 7.
Effects of Amzn015 on antioxidant enzyme activities in A. macrocephala seedlings. (A) Superoxide anion radical (O2−) production. (B) Superoxide dismutase (SOD) activity. (C) Peroxidase (POD) activity. (D) Catalase (CAT) activity. (E) Malondialdehyde (MDA) content. (F. o: F. oxysporum inoculation alone; F. o + Amzn015: combined treatment with Amzn015 and F. oxysporum.) (n = 3). * p < 0.05, ** p < 0.01.
3.6. Amzn015 Activates the Disease Resistance Signaling Network in A. macrocephala
Plants fine-tune these pathways through complex signaling interplay to optimize defense strategies. Figure 8 illustrates that Amzn015 markedly enhances defense-gene expression across all three pathways. In the SA mediated SAR pathway, core genes (ICS, NPR1, PR1, PR2, PR4) showed a pronounced peak at 24 h under the F. o + Amzn015 group, far exceeding levels in the F. o group. Similarly, in the JA/ET dependent ISR pathway, JAR1 and ERF1 were steadily upregulated from 0 to 24 h, and ETR2 expression surged most strongly during the F. o + Amzn015 group. Finally, key phenylpropanoid biosynthesis genes (PAL, C4H, 4CL, CAD) were rapidly induced at 24 h in the Amzn015 group and F. o + Amzn015 group, suggesting an early boost in antimicrobial compound production and cell wall reinforcement. Notably, our data show that in the F.o + Amzn015 group, WRKY22 and WRKY26 were actually downregulated compared to the F.o group alone, indicating that Amzn015 exerts a suppressive effect on these WRKY transcription factors during infection.

Figure 8.
Relative expression levels of key defense-related genes in the SA, JA/ET, and phenylpropanoid pathways in A. macrocephala. (CK: PBS control; F. o: F. oxysporum inoculation alone; Amzn015: Amzn015 treatment alone; F. o + Amzn015: combined treatment with Amzn015 and F. oxysporum.) Expression changes for genes in three defense pathways: SA pathway (ICS, NPR1, PR1, PR2, PR4) (A), JA/ET pathway (JAR1, ERF1, ETR2) (B), WRKY22, WRKY26 in both SA and JA/ET pathway (C), and phenylpropanoid biosynthesis pathway (PAL, C4H, 4CL, CAD) (D). (n = 3). * p < 0.05, ** p < 0.01 compared with the CK group. ## p < 0.01 compared with the F. o group.
4. Discussion
A. macrocephala, one of the “Zhebawei” (eight renowned medicinal herbs of Zhejiang), is widely used for its spleen-strengthening and qi-tonifying properties. However, its large-scale cultivation is increasingly threatened by continuous cropping obstacles, particularly root rot caused by fungal pathogens. Among these, F. oxysporum has been identified as a major causal agent. In agricultural biocontrol, various beneficial microbes have demonstrated promising results. For instance, Bacillus subtilis and certain Trichoderma spp. have been commercialized and successfully applied in field control of cotton Verticillium wilt [27]. Nevertheless, the effectiveness of these exogenously applied microbes in open-field environments is often limited by environmental fluctuations, changes in the rhizosphere microenvironment, and host immune responses. These factors can reduce colonization efficiency and lead to inconsistent biocontrol performance, thereby restricting their broader agricultural application [28]. Additionally, many endophytes possess dual functions in promoting plant growth and enhancing stress tolerance [29], and their ecological safety profile is generally superior to that of exogenous microbial agents. Therefore, the use of endophytic microorganisms represents a highly promising strategy for overcoming continuous cropping obstacles in A. macrocephala cultivation. Their intrinsic compatibility with the host, long-term functional stability, and multifaceted benefits position them as valuable tools in the sustainable and modernized production of medicinal plants.
We isolated Amzn015, a broad-spectrum antifungal endophyte from A. macrocephala, and identified it via morphology, physiological tests, and whole-genome sequencing as Bacillus velezensis. In dual-culture assays, Amzn015 exhibited strong inhibitory activity against key fungal pathogens, including F. oxysporum, E. catenisporum, F. arcuatisporum, and F. foetens. This study suggests that Amzn015 likely inhibits hyphal growth by inactivating F. oxysporum spores and disrupting spore germination. For comparison, on PDA medium, B. velezensis strain B.BV10 achieved approximately 47% mycelial growth inhibition (MGI) against F. oxysporum [30]; whereas our strain Amzn015 showed a stronger suppression rate of 56.9 %. In greenhouse trials, root drenching with Amzn015 reduced root rot severity by 38.8% compared to the F. o group and demonstrated therapeutic effects in already-infected plants, and had a growth recovery effect on already infected plants. This is the first documented use of B. velezensis Amzn015 against root rot in A. macrocephala, offering experimental support for its potential in large-scale medicinal plant disease management.
In addition to disease suppression, Amzn015 demonstrated significant plant growth-promotion (PGP) effects in A. macrocephala [31]. Twenty days of treatment led to notable increases in dry and fresh biomass, shoot height, and root length—indicators of enhanced vigor and stress resilience [32,33]. Remarkably, Amzn015 also restored growth in infected seedlings to levels comparable to healthy controls, aligning with reports that biocontrol strains can aid recovery in pathogen-challenged plants [34]. This dual PGP and biocontrol potential echoes observations in other Bacillus species—such as B. velezensis CE100, which suppresses fungal pathogens via chitinase/β–1, 3–glucanase production while synthesizing IAA to stimulate root growth and improve yield in strawberries. Likewise, B. amyloliquefaciens HF–01 reduced postharvest rot in citrus without sacrificing yield or quality [35]. Thus, B. velezensis Amzn015 not only controls disease but also enhances growth and recovery—offering a compelling case for its integrated use in medicinal plant cultivation, aligning with its multifunctional profiles documented in related Bacillus strains.
Building on the observed mitigation of root rot symptoms, our data further indicate that Amzn015 orchestrates a finely tuned oxidative defense akin to a plant-pathogen biochemical “arms race” in A. macrocephala. Consistent with previous findings that biocontrol inducers modulate activities of key antioxidant enzymes POD, SOD, and CAT during pathogen interaction [36], Amzn015 induced a rapid oxidative burst (0–12 h), marked by elevated O2− and doubled SOD activity [37]. In the following phase (12–48 h), increased POD activity coupled with suppressed CAT maintained H2O2 as a defense signal, while preventing oxidative toxicity. By 48 h, MDA levels were significantly reduced, signaling effective mitigation of lipid peroxidation. This temporally coordinated modulation of ROS production and scavenging reinforces the notion that Amzn015 enhances host defense by amplifying early oxidative responses while minimizing later-stage cellular damage.
The apparent decline in CAT activity observed after Amzn015 treatment—contrary to reports that B. amyloliquefaciens AW3 enhances CAT in poplar [38]—likely reflects differences in pathogen pressure and ROS dynamics. First, Amzn015’s strong antagonism may reduce pathogen-induced oxidative stress, diminishing the need for CAT-mediated detoxification, akin to observations in poplar under milder infection [33]. Second, CAT’s role extends beyond mere ROS clearance—it also participates in redox signaling. Lower CAT activity may support sustained H2O2 signaling while avoiding toxicity, illustrating the complex regulatory balance within plant ROS metabolism. Moreover, Amzn015’s disease suppression is multifactorial—encompassing niche competition, antimicrobial production, immune activation, colonization, and interactions with the host microbiome, all converging to shape the plant’s defense response [39,40].
The present study aimed to determine whether B. velezensis Amzn015 mobilizes host immunity in A. macrocephala during F. oxysporum infection. Gene-expression analysis revealed that Amzn015 significantly upregulated key markers across both the SA-mediated SAR pathway (NPR1, PR1/2/4, ICS) and the JA/ET-associated ISR pathway (JAR1, ERF1, ETR2), surpassing expression levels in the F. o group. Traditionally, SAR and ISR are viewed as antagonistic with SA targeting biotrophs and JA/ET focusing on necrotrophs [41,42,43]. However, emerging evidence shows that beneficial microbes can trigger both pathways simultaneously. These findings suggest that Amzn015 orchestrates a coordinated activation of dual defense mechanisms, reinforcing the plant’s immune response beyond classical pathway separation. Several previous studies have demonstrated positive regulatory roles for WRKY transcription factors in plant defenses. For example, LrWRKY2 from Lilium regale is induced by F. oxysporum infection and hormones such as SA and MeJA [44], and overexpression of LrWRKY2 in transgenic tobacco significantly increases resistance. By contrast, in our F.o + Amzn015 treatment, WRKY22 and WRKY26 were downregulated compared to the F.o group, suggesting that Amzn015 may suppress these specific WRKYs under infection. This disparity may reflect a self–regulatory mechanism in plant immunity, where after initial activation of strong defense responses, certain WRKYs are repressed to balance defense costs, avoid overactivation, or due to feedback from hormone signaling.
This dual activation of SA and JA/ET signaling aligns with emerging evidence that some Bacillus spp., such as Bacillus cereus AR156, can co-activate SAR and ISR through an NPR1-dependent mechanism, thereby providing broad-spectrum protection against diverse pathogens [45]. Similar observations have been reported for B. velezensis BY6, which simultaneously induced both SA and JA/ET mediated pathways in Pterocarya stenoptera, resulting in a combined SAR + ISR defense effect [33]. These findings reinforce the idea that Amzn015 confers multifaceted immune priming by bridging classical pathway boundaries, enhancing host defense flexibility and robustness under fungal attack.
The data highlight that Amzn015 uniquely co-activates both SAR and ISR pathways in A. macrocephala—a rare feature among biocontrol agents. While many beneficial microbes trigger either the SA-dependent SAR or the JA/ET-dependent ISR, Amzn015 elicits sustained upregulation of both sets of marker genes (SA: NPR1, PR1/2/4, ICS; JA/ET: JAR1, ERF1, ETR2) under F. oxysporum challenge. Emerging studies show that such dual-pathway activation, often orchestrated via NPR1-dependent crosstalk, can produce additive or synergistic defense outcomes—supporting robust resistance to both biotrophic and necrotrophic threats [45]. Furthermore, microbial recognition via MAMP-triggered pathways, involving MAPK cascades, may underpin the simultaneous mobilization of SA and JA/ET signaling. Building on these insights, future work will dissect how NPR1 mediates SA-JA/ET integration, map upstream events—such as PRR-MAMP recognition and MAPK activation—and explore hormonal interplay through hormone profiling, transcriptomics, and targeted functional studies. This mechanistic clarity will strengthen the theoretical framework for applying Amzn015 in sustainable, large-scale cultivation of A. macrocephala.
5. Conclusions
This study is the first to show that endophytic B. velezensis Amzn015, isolated from A. macrocephala, combines potent antifungal activity in vitro with effective root rot suppression and growth recovery in infected seedlings. Mechanistically, Amzn015 dynamically modulates ROS metabolism, co-activates SA–JA/ET mediated immune pathways, and boosts phenylpropanoid biosynthesis—resulting in an integrated SAR and ISR defense. These dual benefits in disease resistance and plant vigor, coupled with its safety profile, position Amzn015 as a promising green biocontrol agent, providing a novel microbial resource and mechanistic insights.
Supplementary Materials
The following supporting information can be downloaded at: https://www.mdpi.com/article/10.3390/microorganisms13102300/s1, Figure S1: Phylogenetic tree of three fungal strains constructed based on ITS sequences. Table S1: The primers in this study; Table S2: Antagonistic activities of 10 endophytic bacteria against Fusarium oxysporum in dual culture.
Author Contributions
Conceptualization, N.Z., J.W. and X.Y.; methodology, N.Z. and J.W.; software, N.Z., S.F. and Q.M.; validation, N.Z., S.F., Q.M., S.D. and M.M.; formal analysis, J.W. and S.D.; investigation, N.Z., J.W., S.F., Q.M. and S.D.; resources, X.Y.; data curation, S.F. and M.M.; writing—original draft preparation, N.Z. and J.W.; writing—review and editing, X.Y.; visualization, N.Z., S.F., Q.M. and W.Z.; supervision, W.Z.; project administration, N.Z. and X.Y.; funding acquisition, X.Y. All authors have read and agreed to the published version of the manuscript.
Funding
This research was funded by the National Natural Science Foundation of China, grant number 82173920.
Institutional Review Board Statement
Not applicable.
Informed Consent Statement
Not applicable.
Data Availability Statement
The original data presented in this study are included in this article, and the 16S rRNA gene sequence of the strain are openly available in the National Center for Biotechnology Information (NCBI) database under accession number PV972215. The whole-genome sequence of the strain are openly available in the data NCBI database under accession number PRJNA1294532.
Conflicts of Interest
The authors declare no conflicts of interest.
References
- Commission, N.P. Pharmacopoeia of the People’s Republic of China Part 1; China Medical Science Press: Beijing, China, 2020. [Google Scholar]
- Zhang, M.; Fan, H.; Wang, P. Effects of plant immune inducer “Baokangling No.1” on quality and root rot resistance of Atractylodes macrocephala. Plant Med. 2024, 3, 34–42. [Google Scholar]
- Fan, H.; an, J.; Li, X.; Zhou, J.; Zhao, L.; Ying, Y.; Kai, G. Atractylodes macrocephala Root Rot Affects Microbial Communities in Various Root-Associated Niches. Agronomy 2024, 14, 2662. [Google Scholar] [CrossRef]
- Zhu, B.; Wu, J.; Ji, Q.; Wu, W.; Dong, S.; Yu, J.; Zhang, Q.; Qin, L. Diversity of rhizosphere and endophytic fungi in Atractylodes macrocephala during continuous cropping. PeerJ 2020, 8, e8905. [Google Scholar] [CrossRef]
- Huang, X.G.; Li, M.Y.; Yan, X.N.; Yang, J.S.; Rao, M.C.; Yuan, X.F. The potential of Trichoderma brevicompactum for controlling root rot on Atractylodes macrocephala. Can. J. Plant Pathol. 2021, 43, 794–802. [Google Scholar] [CrossRef]
- Al Raish, S.M.; Sourani, O.M.; Abu-Elsaoud, A.M. Plant Growth-Promoting Microorganisms as Biocontrol Agents: Mechanisms, Challenges, and Future Prospects. Appl. Microbiol. 2025, 5, 44. [Google Scholar] [CrossRef]
- Ren, Z.; Xie, L.; Okyere, S.K.; Wen, J.; Ran, Y.; Nong, X.; Hu, Y. Antibacterial Activity of Two Metabolites Isolated From Endophytic Bacteria Bacillus velezensis Ea73 in Ageratina adenophora. Front. Microbiol. 2022, 13, 860009. [Google Scholar] [CrossRef] [PubMed]
- Nanjani, S.; Soni, R.; Paul, D.; Keharia, H. Genome analysis uncovers the prolific antagonistic and plant growth-promoting potential of endophyte Bacillus velezensis K1. Gene 2022, 836, 146671. [Google Scholar] [CrossRef] [PubMed]
- Ji, C.; Wang, X.; Song, X.; Zhou, Q.; Li, C.; Chen, Z.; Gao, Q.; Li, H.; Li, J.; Zhang, P.; et al. Effect of Bacillus velezensis JC-K3 on Endophytic Bacterial and Fungal Diversity in Wheat Under Salt Stress. Front. Microbiol. 2021, 12, 802054. [Google Scholar] [CrossRef]
- Han, V.C.; Yu, N.H.; Yoon, H.; Ahn, N.H.; Son, Y.K.; Lee, B.H.; Kim, J.C. Identification, Characterization, and Efficacy Evaluation of Bacillus velezensis for Shot-Hole Disease Biocontrol in Flowering Cherry. Plant Pathol. J. 2022, 38, 115–130. [Google Scholar] [CrossRef]
- Kim, S.; Kim, H.M.; Yang, J.E.; Jeong, S.-G.; Kim, Y.Y.; Hwang, I.M.; Yu, N.H.; Kim, J.-C.; Park, H.W. Biological control of the shot-hole disease in flowering cherry tree using antimicrobial compounds produced by Bacillus velezensis 8–2. Chem. Biol. Technol. Agric. 2024, 11, 87. [Google Scholar] [CrossRef]
- Wang, J.; Qu, F.; Liang, J.; Yang, M.; Hu, X. Bacillus velezensis SX13 promoted cucumber growth and production by accelerating the absorption of nutrients and increasing plant photosynthetic metabolism. Sci. Hortic. 2022, 301, 111151. [Google Scholar] [CrossRef]
- Ta, Y.; Fu, S.; Liu, H.; Zhang, C.; He, M.; Yu, H.; Ren, Y.; Han, Y.; Hu, W.; Yan, Z.; et al. Evaluation of Bacillus velezensis F9 for Cucumber Growth Promotion and Suppression of Fusarium wilt Disease. Microorganisms 2024, 12, 1882. [Google Scholar] [CrossRef]
- Zhang, J.; Islam, M.S.; Wang, J.; Zhao, Y.; Dong, W. Isolation of Potato Endophytes and Screening of Chaetomium globosum Antimicrobial Genes. Int. J. Mol. Sci. 2022, 23, 4611. [Google Scholar] [CrossRef]
- Skidmore, A.M.; Dickinson, C.H. Colony interactions and hyphal interference between Septoria nodorum and phylloplane fungi. Trans. Br. Mycol. Soc. 1976, 66, 57–64. [Google Scholar] [CrossRef]
- Jin, M.J.; Li, S.S.; Tian, W.B.; Yang, C.D.; Wang, Y.Q. Screening, identification and detection of growth-promoting antagonistic endophytic bacteria from Carex moorcroftii in alpine grassland. J. Plant Prot. 2019, 46, 779–786. [Google Scholar]
- Kumar, S.; Yadav, A.K.; Chambel, P.; Kaur, R. Molecular and functional characterization of myxobacteria isolated from soil in India. 3 Biotech. 2017, 7, 112. [Google Scholar] [CrossRef] [PubMed]
- Dinesh, R.; Anandaraj, M.; Kumar, A.; Bini, Y.K.; Subila, K.P.; Aravind, R. Isolation, characterization, and evaluation of multi-trait plant growth promoting rhizobacteria for their growth promoting and disease suppressing effects on ginger. Microbiol. Res. 2015, 173, 34–43. [Google Scholar] [CrossRef] [PubMed]
- Tiwari, S.; Sarangi, B.K.; Thul, S.T. Identification of arsenic resistant endophytic bacteria from Pteris vittata roots and characterization for arsenic remediation application. J. Env. Manag. 2016, 180, 359–365. [Google Scholar] [CrossRef]
- Harding, M.W.; Hill, T.B.; Yang, Y.; Daniels, G.C.; Hwang, S.F.; Strelkov, S.E.; Howard, R.J.; Feng, J. An Improved Evans Blue Staining Method for Consistent, Accurate Assessment of Plasmodiophora brassicae Resting Spore Viability. Plant Dis. 2019, 103, 2330–2336. [Google Scholar] [CrossRef] [PubMed]
- Gupta, S.; Pandey, S.; Sharma, S. Decoding the Plant Growth Promotion and Antagonistic Potential of Bacterial Endophytes From Ocimum sanctum Linn. Against Root Rot Pathogen Fusarium oxysporum in Pisum sativum. Front. Plant Sci. 2022, 13, 813686. [Google Scholar] [CrossRef]
- Rewers, M.; Sliwinska, E. Endoreduplication intensity as a marker of seed developmental stage in the Fabaceae. Cytom. A 2012, 81, 1067–1075. [Google Scholar] [CrossRef]
- Tang, Y.; Li, R.; Jiang, Z.; Cheng, Z.; Li, W.; Shao, Y. Combined effect of Debaryomyces hansenii and Bacillus atrophaeus on the physicochemical attributes, defense-related enzyme activity, and transcriptomic profile of stored litchi fruit. Biol. Control 2022, 172, 104975. [Google Scholar] [CrossRef]
- Sultana, S.; Adhikary, S.K.; Islam, M.M.; Rahman, S.M.M. Evaluation of Pathogenic Variability Based on Leaf Blotch Disease Development Components of Bipolaris sorokiniana in Triticum aestivum and Agroclimatic Origin. Plant Pathol. J. 2018, 34, 93–103. [Google Scholar] [CrossRef] [PubMed]
- Fan, S.; Tang, Y.; Zhu, N.; Meng, Q.; Zhou, Y.; Zhao, Y.; Xu, J.; Gu, C.; Dai, S.; Zhu, B.; et al. Analyzing the defense response mechanism of Atractylodes macrocephala to Fusarium oxysporum through small RNA and degradome sequencing. Front. Plant Sci. 2024, 15, 1415209. [Google Scholar] [CrossRef]
- Bubner, B.; Baldwin, I.T. Use of real-time PCR for determining copy number and zygosity in transgenic plants. Plant Cell Rep. 2004, 23, 263–271. [Google Scholar] [CrossRef] [PubMed]
- Zhu, H.; Li, Z.; Feng, Z.; Feng, H.; Wei, F.; Zhao, L. Overview of cotton Verticillium wilt research over the past decades in China and its Prospect in future. Cotton Sci. 2017, 29, 37–50. [Google Scholar]
- Zhalnina, K.; Louie, K.B.; Hao, Z.; Mansoori, N.; da Rocha, U.N.; Shi, S.; Cho, H.; Karaoz, U.; Loque, D.; Bowen, B.P.; et al. Dynamic root exudate chemistry and microbial substrate preferences drive patterns in rhizosphere microbial community assembly. Nat. Microbiol. 2018, 3, 470–480. [Google Scholar] [CrossRef]
- Abdelmoteleb, A.; Moreno-Ramirez, L.; Valdez-Salas, B.; Seleiman, M.F.; El-Hendawy, S.; Aldhuwaib, K.J.; Alotaibi, M.; Gonzalez-Mendoza, D. New Bacillus subtilis Strains Isolated from Prosopis glandulosa Rhizosphere for Suppressing Fusarium Spp. and Enhancing Growth of Gossypium hirsutum L. Biology 2022, 12, 73. [Google Scholar] [CrossRef]
- Berte, R.; Teixeira, G.M.; de Oliveira, J.P.; Nicoletto, M.L.A.; da Silva, D.V.; de Godoy, G.G.; Sanches, D.S.; de Resende, J.T.V.; Pereira, U.P.; Nunes da Rocha, U.; et al. Genome Mining Reveals High Biosynthetic Potential of Biocontrol Agent Bacillus velezensis B.BV10. Genes 2022, 13, 1984. [Google Scholar] [CrossRef]
- Zhang, X.; Kong, W.; Wu, X.; Ye, J. Bacillus velezensis JK-XZ8 prevents and controls crown gall disease on Prunus subhirtella by colonizing and inducing resistance. J. For. Res. 2021, 33, 1019–1031. [Google Scholar] [CrossRef]
- Ji, C.; Zhang, M.; Kong, Z.; Chen, X.; Wang, X.; Ding, W.; Lai, H.; Guo, Q. Genomic Analysis Reveals Potential Mechanisms Underlying Promotion of Tomato Plant Growth and Antagonism of Soilborne Pathogens by Bacillus amyloliquefaciens Ba13. Microbiol. Spectr. 2021, 9, e0161521. [Google Scholar] [CrossRef]
- Zhang, P.; Xie, G.; Wang, L.; Xing, Y. Bacillus velezensis BY6 Promotes Growth of Poplar and Improves Resistance Contributing to the Biocontrol of Armillaria solidipes. Microorganisms 2022, 10, 2472. [Google Scholar] [CrossRef]
- Jin, W.; Peng, L.; Zhang, X.; Sun, H.; Yuan, Z. Effects of endophytic and ectomycorrhizal basidiomycetes on Quercus virginiana seedling growth and nutrient absorption. J. Sustain. For. 2019, 38, 457–470. [Google Scholar] [CrossRef]
- Hong, P.; Hao, W.; Luo, J.; Chen, S.; Hu, M.; Zhong, G. Combination of hot water, Bacillus amyloliquefaciens HF-01 and sodium bicarbonate treatments to control postharvest decay of mandarin fruit. Postharvest Biol. Technol. 2014, 88, 96–102. [Google Scholar] [CrossRef]
- Saijo, Y.; Loo, E.P.; Yasuda, S. Pattern recognition receptors and signaling in plant-microbe interactions. Plant J. 2018, 93, 592–613, Erratum in Plant J. 2018, 94, 450. [Google Scholar] [CrossRef]
- Zhou, X.; Li, R.; Shen, H.; Yang, L. Effect of Exogenous Plant Growth Regulators and Rejuvenation Measures on the Endogenous Hormone and Enzyme Activity Responses of Acer mono Maxim in Cuttage Rooting. Int. J. Mol. Sci. 2023, 24, 11883. [Google Scholar] [CrossRef] [PubMed]
- Zhang, P.; Hao, H.; Wang, L.; Liu, Z.; Ma, L. Endophytes Bacillus amyloliquefaciens AW3 (CGMCC1.16683) improves the growth of Populus davidiana × Populus bolleana (PdPap) and induces its resistance to wilt disease by Fusarium oxysporum Fox68 (CFCC86068). Eur. J. Plant Pathol. 2021, 162, 1–17. [Google Scholar] [CrossRef]
- Wang, X.; Liang, L.; Shao, H.; Ye, X.; Yang, X.; Chen, X.; Shi, Y.; Zhang, L.; Xu, L.; Wang, J. Isolation of the Novel Strain Bacillus amyloliquefaciens F9 and Identification of Lipopeptide Extract Components Responsible for Activity against Xanthomonas citri subsp. citri. Plants 2022, 11, 457. [Google Scholar] [CrossRef] [PubMed]
- Zhang, Y.; Qin, B.; Narisawa, K.; Nong, Q.; Qin, L.; Xie, L. The Dark Septate Endophyte, Phialocephala fortinii J2PC4, Mitigates Southern Rice Black-Streaked Dwarf Disease and Impacts the Mortality of White Back Planthopper. Biol. Control 2022, 170, 104911. [Google Scholar] [CrossRef]
- De Vleesschauwer, D.; Gheysen, G.; Hofte, M. Hormone defense networking in rice: Tales from a different world. Trends Plant Sci. 2013, 18, 555–565. [Google Scholar] [CrossRef]
- Kalsi, H.S.; Karkhanis, A.A.; Natarajan, B.; Bhide, A.J.; Banerjee, A.K. AUXIN RESPONSE FACTOR 16 (StARF16) regulates defense gene StNPR1 upon infection with necrotrophic pathogen in potato. Plant Mol. Biol. 2022, 109, 13–28. [Google Scholar] [CrossRef] [PubMed]
- Yang, Y.; Qi, M.; Mei, C. Endogenous salicylic acid protects rice plants from oxidative damage caused by aging as well as biotic and abiotic stress. Plant J. 2004, 40, 909–919. [Google Scholar] [CrossRef] [PubMed]
- Li, S.; Hai, J.; Wang, Z.; Deng, J.; Liang, T.; Su, L.; Liu, D. Lilium regale Wilson WRKY2 Regulates Chitinase Gene Expression During the Response to the Root Rot Pathogen Fusarium oxysporum. Front. Plant Sci. 2021, 12, 741463. [Google Scholar] [CrossRef]
- Yu, Y.; Gui, Y.; Li, Z.; Jiang, C.; Guo, J.; Niu, D. Induced Systemic Resistance for Improving Plant Immunity by Beneficial Microbes. Plants 2022, 11, 386. [Google Scholar] [CrossRef] [PubMed]
Disclaimer/Publisher’s Note: The statements, opinions and data contained in all publications are solely those of the individual author(s) and contributor(s) and not of MDPI and/or the editor(s). MDPI and/or the editor(s) disclaim responsibility for any injury to people or property resulting from any ideas, methods, instructions or products referred to in the content. |
© 2025 by the authors. Licensee MDPI, Basel, Switzerland. This article is an open access article distributed under the terms and conditions of the Creative Commons Attribution (CC BY) license (https://creativecommons.org/licenses/by/4.0/).








